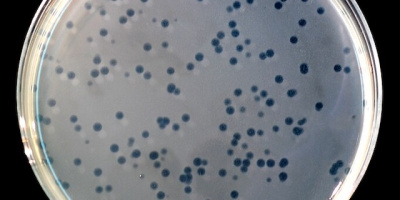
Mjukagar

LB (Luriabuljong)

-
Lös
- 10,0 g trypton
- 5,0 g jästextrakt
- 5,0 g NaCl
i 1000 ml destillerat eller avjonat vatten - Autoklavera lösningen så snart som möjligt.
- Den autoklaverade lösningen kan förvaras i en lufttät behållare i kylskåp i åtminstone sex månader.
LA (Luriaagar)
- Blanda
- 10,0 g trypton
- 5,0 g jästextrakt
- 5,0 g NaCl
- 10,0 g agar
- Värm tills all agar smält, och du fått en homogen lösning.
- Autoklavera lösningen så snart som möjligt.
- Den autoklaverade agarn kan förvaras i en lufttät behållare i kylskåp i åtminstone sex månader.